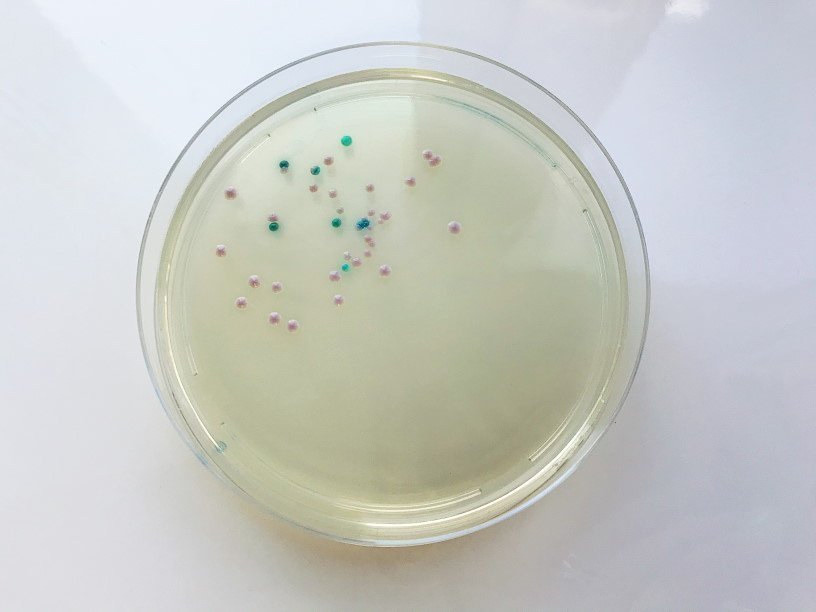

Екатерина Беленко: Промикробы: Некоторые любят погорячее
Грибки Candida двух видов в чашке Петри Фото: Екатерина Беленко Пока одни радуются теплой и бесснежной зиме, а другие печалятся и предрекают снежный апокалипсис в марте, я снова задумалась о температурных предпочтениях братьев наших меньших. И я не о собачках. По температурному оптимуму роста выделяют три основные группы микроорганизмов.
1. Психрофилы — растут при температурах ниже +20 градусов Цельсия.
2. Мезофилы — растут в диапозоне температур от 20 до 45 градусов (часто оптимальная температура для них — это 37 градусов С).
3. Термофилы — растут при температурах выше плюс 45 градусов.
⠀
Очевидно, что я, как и все медицинские микробиологи, работаю исключительно со второй категорией. Любители холода или жары не станут селиться в или на теле человека. Вот грибочки рода Кандида, которыми вы можете полюбоваться (два вида красавчиков на фото), предпочитают чуть более прохладную обстановку. Тест-системы для их идентификации нужно инкубировать при 30 градусах, а не при 37, как все остальные любят. Еще необходимо разграничивать два понятия — «живут» и «выживают». Описанные выше три категории — это именно про комфортные для жизни и размножения градусы. А выжить, хоть чучелом, хоть тушкой, бактерии могут при гораздо более высоких и гораздо более низких температурах.
Знать пределы выживаемости микробиков важно не только из научного любопытства, но и для прикладных целей. Например, чтобы их успешно убить. После того как посев изучен, возбудитель идентифицирован, антибиотикочувствительность определена, чашки Петри с их жильцами становятся нам не нужны. Но их нельзя просто выкинуть, сначала жильцов этих надо убить. Правда, не все микроорганизмы так легко дают убить себя насмерть, поэтому мы применяем автоклавы — мультиварки промышленных масштабов. В них, кроме высокой температуры (132 градуса Цельсия), еще и нагнетается повышенное атмосферное давление, чтобы уж наверняка. Пластик не выдерживает, не то что одноклеточная поросль.
⠀
Затем полученная смесь из убитых микробов, расплавленных чашек Петри и повторно застывших питательных сред с чистой совестью утилизируется — никакой опасности она уже не представляет. Хотя нет, представляет — пахнет просто жутко. Если вы думали, что самое большое испытание для обоняния — это моча, принесенная на посев, вы сильно заблуждались.